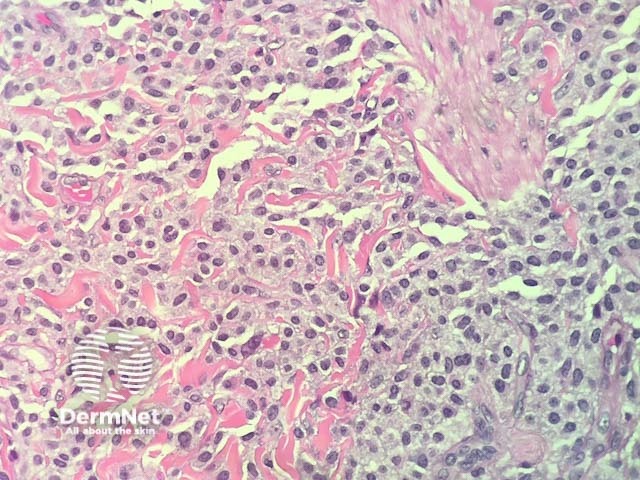
Figure 4

Main menu
Common skin conditions
NEWS
Join DermNet PRO
Read more
Quick links
Author: Adjunct A/Prof Patrick Emanuel, Dermatopathologist, Clínica Ricardo Palma, Lima, Peru. DermNet Editor in Chief: Adjunct A/Prof Amanda Oakley. October 2018.
Introduction Histology Special studies Differential diagnoses
Maculopapular cutaneous mastocytosis was previously called urticaria pigmentosa. It is the most common form of mastocytosis in adults and children.
Maculopapular mastocytosis in adults is unlikely to resolve with time. It may rarely lead to systemic involvement, where the mastocytosis spreads to more than one tissue.
In maculopapular cutaneous mastocytosis, the histopathology shows an accumulation of mast cells in the dermis (figures 1-4). Mast cells are round or spindle shaped with abundant eosinophilic cytoplasm which contain minute granules, distinct cytoplasmic boundaries, and large pale nuclei (best seen in figures 2-4). Often there are accompanying other inflammatory cells including histiocytes, eosinophils and lymphocytes. There may be oedema of the dermis, particularly if the lesion has been traumatised.

Figure 1

Figure 2

Figure 3
Figure 4
Giemsa, toluidine blue , tryptase, and Leder special stains can help highlight the mast cells. Immunohistochemistry with CD117 is very helpful in difficult cases, as this nicely highlights the mast cells.
Other diagnoses to be considered include:
Kelly JV. Generalized, well-dispersed rash · wheal development after tactile irritation · normal vital signs · Dx? J Fam Pract. 2015 Oct;64(10):645–7. PubMed PMID: 26551471.